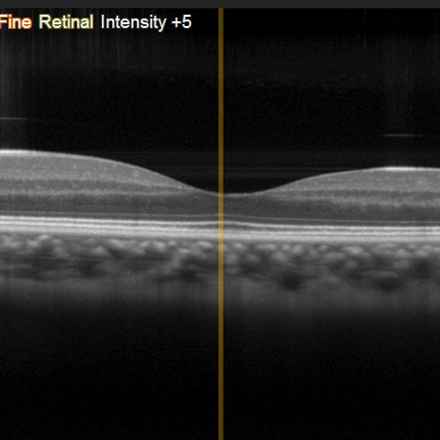
OCT scan

Investigating factors involved in rate of AMD progression
Professor Adam Dubis, University College London - £244,860
This project aims to investigate which gene mutations may be involved in why those with age-related macular degeneration (AMD) experience differences in the rate of disease progression. Using artificial intelligence, the researchers aim to generate a way to subgroup patients based on genetic risk factors to better understand risk of progression.
What is the problem?
There is wide variation in the rate at which AMD progresses. Some people convert from early AMD to late AMD relatively quickly, while others with early AMD will never go on to develop late AMD even after many years. This means it is difficult to give patients a timeline for their condition and, as new treatments come through, it is harder to know who will react well to a treatment and who won’t.
What are they doing?
Research has shown genetics can play a role in AMD disease progression. This work aims to use state of the art artificial intelligence software and clinical data including OCT images (like the one shown in the above picture) from large groups of AMD patients to characterise patients into subgroups, to find links between disease progression and genetic risk.
How can this help?
This work will help to understand what drives the rate at which AMD progresses from the early to late stages. It will help identify which patients may be most suitable for treatments, which could lead to more successful clinical trials. It could also give patients a better understanding of their condition and what treatments may be best suited for them.
See our other projects
Since 1987 the Macular Society has invested around £10 million in over 100 research projects.
Explore more research
Beating macular disease through funding medical research and improving the lives of those living with macular disease.

Get the latest research news from the Macular Society
To hear about life-changing research and treatments, subscribe to our monthly enewsletter today. Together we can Beat Macular Disease.
Sign up to our free email newsletter